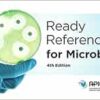
Ready Reference for Microbes, 4th Edition (PDF) Ready Reference for Microbes, 4th Edition (PDF)

by the Association for Professionals in Infection Control and Epidemiology, Inc. (APIC)
The Infection Preventionist’s Guide to the Lab
Product Details
Publisher : APIC
Language : English
ISBN-10 : 1933013524
ISBN-13 : 978-1933013527
Best Sellers Rank: #1,622,282 in Books (See Top 100 in Books)

Reviews
There are no reviews yet.